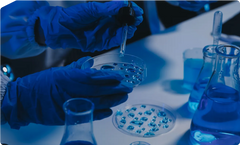

Clinically Tested
Intertek
ISO Certified
GMP Certified
Kosher Certification
Halal Certified
Explore Decode Age’s Premier Health Solutions.
Explore Decode Age’s Premier Health Solutions.




















Decode Age is held to the highest quality standards. From procurement to sales, we ensure rigorous testing and conducted in an FDA-registered facility, we strictly adhere to Good Manufacturing Practices (GMP) for maximum safety and efficacy.
Our supplements are crafted with ingredients researched extensively and chosen based on recent scientific studies to ensure optimal health benefits.
We source ingredients from trusted suppliers, ensuring high quality. Each is vetted to be contaminant-free, meeting our rigorous standards for the best results.
We partner with independent labs to rigorously test all products, confirming their purity, potency, and safety—ensuring you can trust what you consume.
Decode Age ensures top data protection, following Agile Data Compliance with HIPAA, GDPR, and HITRUST CSF, protecting customer data to global standards
Clinically Tested
Intertek
ISO Certified
GMP Certified
Kosher Certification
Halal Certified
Featured on






























Decode Age is primarily focused on being India's premier longevity ecosystem. We specialize in making the latest scientific advancements in ageing science accessible to every Indian.
Our distinctiveness lies in our commitment to research, quality, personalized and science-backed approach. We are the first company in India to offer the advanced Metagenomic Gut Microbiome test, and we house a state-of-the-art Next-Generation Sequencing (NGS) Lab, positioning us at the forefront of microbiome research.
Decode Age is India's First Longevity Company. With our science-backed supplements and by integrating technology at various fronts, we aim to redefine ageing.
Decode Age was founded by Parth Amin, Darshit Patel, and Rakesh Somani, all of whom come from diverse backgrounds and are united by their passion for longevity and health. They aim at making Ageless Living a reality for everyone.
Lifespan is the number of years you live, while healthspan is the number of years you live in good health, free from chronic diseases. Healthy ageing means increasing the number of healthy years in one's life; that is what we offer at Decode Age. With our longevity solutions, you can age gracefully and add more healthy years to your life.
Yes, we ship worldwide.
Cash on Delivery (COD) is available, allowing you to pay at the time of delivery. A ₹99 advance confirmation fee is required to place the order, and the remaining amount can be paid to the delivery partner upon receiving the product.
Most of our supplements are bio enzymes and plant-based. One may experience certain temporary side effects such as nausea, flushing, or headaches. This is normal: when something new is introduced into your routine, it can take time for your body to adapt. No long-term adverse effects have been reported so far.
You can use them as they have no negative interactions with any kind of medicine. However, please consult with your healthcare provider before starting the supplementation if you are facing a serious health issue.
Scientists around the globe have been studying ageing for several decades. This research has yielded numerous interventions that can be utilized by humans to tackle the ageing process at a biological level. Our supplements and tests are among these interventions, drawing on extensive global research in the field of ageing sciences.
Along with supplements, we emphasize a healthy lifestyle. We encourage you to eat well, sleep adequately, and exercise regularly. Avoid habits that accelerate ageing, such as smoking and excessive alcohol consumption.
Remember, hard choices lead to an easy life. Make your life easier by keeping your physical health as good as possible for as long as possible.

PMOS vs PCOS: Why the Name Change Matters for Women’s Metabolic Health
PCOS is now officially PMOS. We explain what this landmark renaming means for women's metabolic health, insulin resistance, inflammation, and long-term longevity.

How to Improve Weak Immunity: Supplements That Actually Work
Learn how to improve weak immunity with supplements like NMN, vitamin D, zinc, and magnesium. Support immune resilience, recovery, and long-term health.

Why You Fall Sick More Often as You Get Older
Learn why immunity weakens with age due to inflammation and NAD+ decline. Explore ways to support immune resilience and recovery naturally.

Brain Fog After 35: Nutritional Causes & Solutions
Understand causes of brain fog after 35 and how nutrition, sleep, gut health, and NAD+ support can improve mental clarity, memory, and long-term brain health.